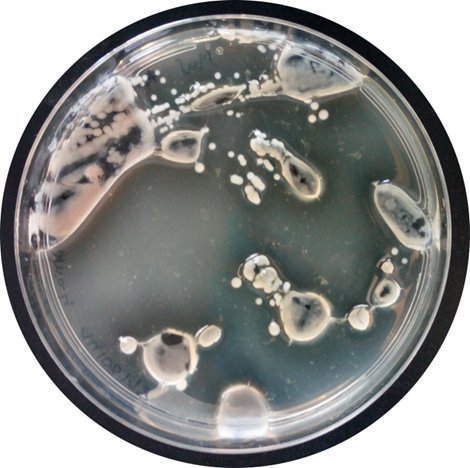
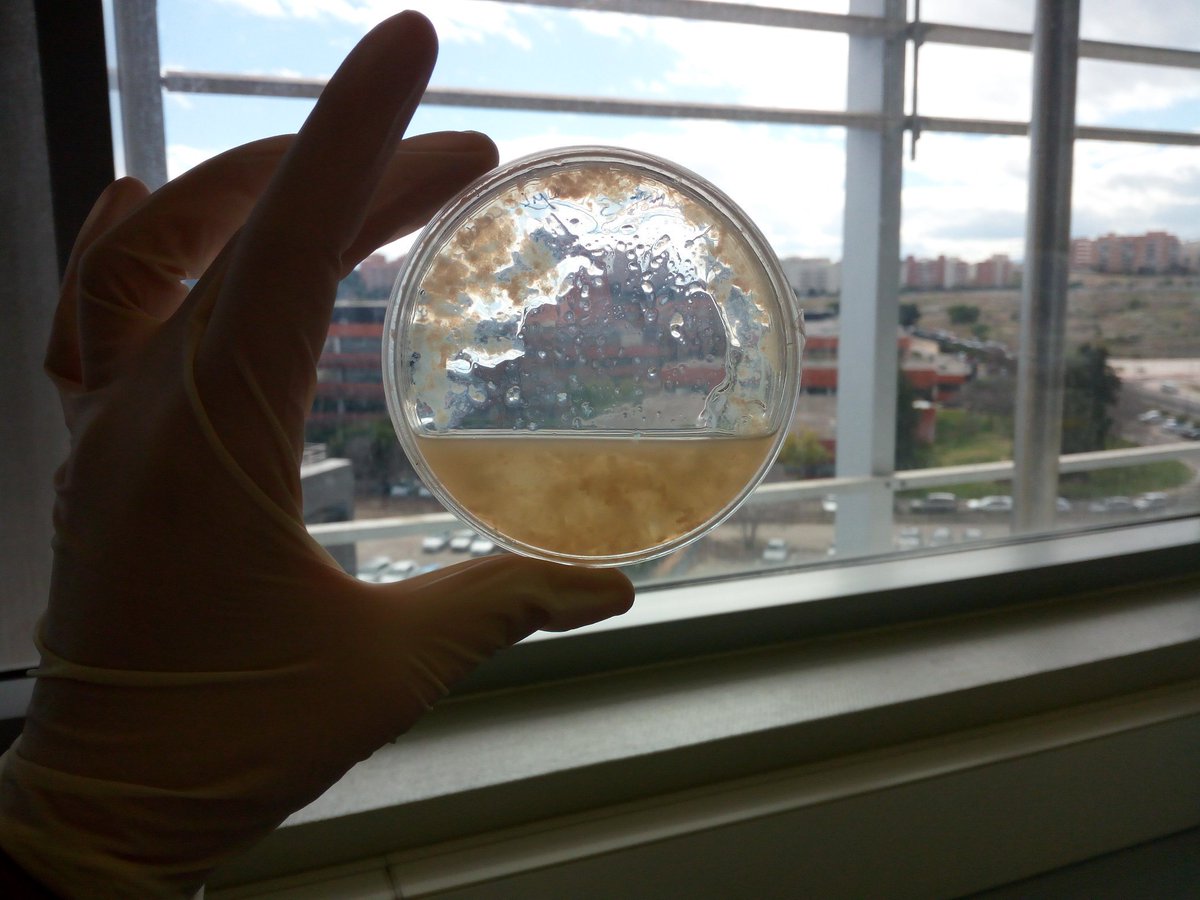

ಟ್ವೀಟ್ಗಳು
- ಟ್ವೀಟ್ಗಳು, ಪ್ರಸ್ತುತ ಪುಟ.
- ಟ್ವೀಟ್ಗಳು & ಪ್ರತಿಕ್ರಿಯೆಗಳು
- ಮಾಧ್ಯಮ
ನೀವು @BMCS88 ಅವರನ್ನು ತಡೆಹಿಡಿದಿರುವಿರಿ
ಈ ಟ್ವೀಟ್ಗಳನ್ನು ವೀಕ್ಷಿಸಲು ನೀವು ಖಚಿತವಾಗಿ ಬಯಸುವಿರಾ? ಟ್ವೀಟ್ ವೀಕ್ಷಣೆಯು @BMCS88 ಅವರ ತಡೆತೆರವುಗೊಳಿಸುವುದಿಲ್ಲ
-
Melissa
ಧನ್ಯವಾದಗಳು. Twitter ಇದನ್ನು ನಿಮ್ಮ ಕಾಲರೇಖೆಯನ್ನು ಉತ್ತಮಗೊಳಿಸಲು ಬಳಸುತ್ತದೆ. ರದ್ದುಗೊಳಿಸುರದ್ದುಗೊಳಿಸು -
Ben Swift ಅವರು ಮರುಟ್ವೀಟಿಸಿದ್ದಾರೆ
Badger cull alone won't eradicate bovine TB, says
@MalcolmBennett7, but this might... http://ow.ly/tzSG30mT7DW#badgers#bovineTB@NottinghamVetspic.twitter.com/y6ZgtHFQf5 ಧನ್ಯವಾದಗಳು. Twitter ಇದನ್ನು ನಿಮ್ಮ ಕಾಲರೇಖೆಯನ್ನು ಉತ್ತಮಗೊಳಿಸಲು ಬಳಸುತ್ತದೆ. ರದ್ದುಗೊಳಿಸುರದ್ದುಗೊಳಿಸು
ಧನ್ಯವಾದಗಳು. Twitter ಇದನ್ನು ನಿಮ್ಮ ಕಾಲರೇಖೆಯನ್ನು ಉತ್ತಮಗೊಳಿಸಲು ಬಳಸುತ್ತದೆ. ರದ್ದುಗೊಳಿಸುರದ್ದುಗೊಳಿಸು -
Ben Swift ಅವರು ಮರುಟ್ವೀಟಿಸಿದ್ದಾರೆ
New group paper out today! A study of tuberculosis in road-kill badgers on the edge of the British bovine TB epidemic.
@MalcolmBennett7 @neofelis_elsa @BMCS88https://www.nature.com/articles/s41598-018-35652-5 …ಧನ್ಯವಾದಗಳು. Twitter ಇದನ್ನು ನಿಮ್ಮ ಕಾಲರೇಖೆಯನ್ನು ಉತ್ತಮಗೊಳಿಸಲು ಬಳಸುತ್ತದೆ. ರದ್ದುಗೊಳಿಸುರದ್ದುಗೊಳಿಸು -
Ben Swift ಅವರು ಮರುಟ್ವೀಟಿಸಿದ್ದಾರೆ
We've deleted an earlier version of this video that incorrectly described Sir David Attenborough as a 'naturist.' We of course meant to describe him as a naturalist. We regret the error.
ಈ ಥ್ರೆಡ್ ತೋರಿಸಿಧನ್ಯವಾದಗಳು. Twitter ಇದನ್ನು ನಿಮ್ಮ ಕಾಲರೇಖೆಯನ್ನು ಉತ್ತಮಗೊಳಿಸಲು ಬಳಸುತ್ತದೆ. ರದ್ದುಗೊಳಿಸುರದ್ದುಗೊಳಿಸು -
Ben Swift ಅವರು ಮರುಟ್ವೀಟಿಸಿದ್ದಾರೆ
We were pleased to see
@PBDBiotech in the news - they are the first#AgriTech company to enter the@businessweekly awards - read more here:http://ow.ly/xs4z30mNGloಧನ್ಯವಾದಗಳು. Twitter ಇದನ್ನು ನಿಮ್ಮ ಕಾಲರೇಖೆಯನ್ನು ಉತ್ತಮಗೊಳಿಸಲು ಬಳಸುತ್ತದೆ. ರದ್ದುಗೊಳಿಸುರದ್ದುಗೊಳಿಸು -
Ben Swift ಅವರು ಮರುಟ್ವೀಟಿಸಿದ್ದಾರೆ
PBD Biotech Recognised At Norfolk Business Awards – CEO Berwyn Clarke says: "We established
@PBDBiotech less than two years ago, so to be recognised is a real testament to how far we’ve already come." http://www.pbdbio.com/news/pbd-biotech-recognised-at-norfolk-business-awards/ …#edpbizawardspic.twitter.com/QNyiCLHgDB ಧನ್ಯವಾದಗಳು. Twitter ಇದನ್ನು ನಿಮ್ಮ ಕಾಲರೇಖೆಯನ್ನು ಉತ್ತಮಗೊಳಿಸಲು ಬಳಸುತ್ತದೆ. ರದ್ದುಗೊಳಿಸುರದ್ದುಗೊಳಿಸು
ಧನ್ಯವಾದಗಳು. Twitter ಇದನ್ನು ನಿಮ್ಮ ಕಾಲರೇಖೆಯನ್ನು ಉತ್ತಮಗೊಳಿಸಲು ಬಳಸುತ್ತದೆ. ರದ್ದುಗೊಳಿಸುರದ್ದುಗೊಳಿಸು -
Ben Swift ಅವರು ಮರುಟ್ವೀಟಿಸಿದ್ದಾರೆ
Is this the best example ever of a
#PushyParent?https://www.bbc.co.uk/news/uk-wales-46155437 …ಧನ್ಯವಾದಗಳು. Twitter ಇದನ್ನು ನಿಮ್ಮ ಕಾಲರೇಖೆಯನ್ನು ಉತ್ತಮಗೊಳಿಸಲು ಬಳಸುತ್ತದೆ. ರದ್ದುಗೊಳಿಸುರದ್ದುಗೊಳಿಸು -
Ben Swift ಅವರು ಮರುಟ್ವೀಟಿಸಿದ್ದಾರೆ
New test delivers early identification of TB in exotic animals | PBD Biotechhttp://www.pbdbio.com/news/new-test-delivers-early-identification-tb-exotics/ …
ಧನ್ಯವಾದಗಳು. Twitter ಇದನ್ನು ನಿಮ್ಮ ಕಾಲರೇಖೆಯನ್ನು ಉತ್ತಮಗೊಳಿಸಲು ಬಳಸುತ್ತದೆ. ರದ್ದುಗೊಳಿಸುರದ್ದುಗೊಳಿಸು -
Ben Swift ಅವರು ಮರುಟ್ವೀಟಿಸಿದ್ದಾರೆ
Rapid Detection of TB in Wildlife and Exotic Animals Using Actiphage with Benjamin Swift at
#BVZS Conference 2018pic.twitter.com/SlHU6WscaH
 ಧನ್ಯವಾದಗಳು. Twitter ಇದನ್ನು ನಿಮ್ಮ ಕಾಲರೇಖೆಯನ್ನು ಉತ್ತಮಗೊಳಿಸಲು ಬಳಸುತ್ತದೆ. ರದ್ದುಗೊಳಿಸುರದ್ದುಗೊಳಿಸು
ಧನ್ಯವಾದಗಳು. Twitter ಇದನ್ನು ನಿಮ್ಮ ಕಾಲರೇಖೆಯನ್ನು ಉತ್ತಮಗೊಳಿಸಲು ಬಳಸುತ್ತದೆ. ರದ್ದುಗೊಳಿಸುರದ್ದುಗೊಳಿಸು -
Ben Swift ಅವರು ಮರುಟ್ವೀಟಿಸಿದ್ದಾರೆ
PBD Biotech secures grant of key patent for its new bacterial diagnostic technology https://www.angelnews.co.uk/blog/health/pbd-biotech-secures-grant-of-key-patent-for-its-new-bacterial-diagnostic-technology/ …
ಧನ್ಯವಾದಗಳು. Twitter ಇದನ್ನು ನಿಮ್ಮ ಕಾಲರೇಖೆಯನ್ನು ಉತ್ತಮಗೊಳಿಸಲು ಬಳಸುತ್ತದೆ. ರದ್ದುಗೊಳಿಸುರದ್ದುಗೊಳಿಸು -
Ben Swift ಅವರು ಮರುಟ್ವೀಟಿಸಿದ್ದಾರೆ
Officers, I swear it wasn't me. As you can see, I was in New York. To the hardworking Blackpool Police, good luck with the investigation.
#itwasntmepic.twitter.com/EDFF9dZoYRಧನ್ಯವಾದಗಳು. Twitter ಇದನ್ನು ನಿಮ್ಮ ಕಾಲರೇಖೆಯನ್ನು ಉತ್ತಮಗೊಳಿಸಲು ಬಳಸುತ್ತದೆ. ರದ್ದುಗೊಳಿಸುರದ್ದುಗೊಳಿಸು -
Ben Swift ಅವರು ಮರುಟ್ವೀಟಿಸಿದ್ದಾರೆ
New phage test gives early detection of Johne’s disease in newborn calves - News - http://VetSurgeon.org https://www.vetsurgeon.org/news/b/veterinary-news/archive/2018/10/15/new-phage-test-gives-early-detection-of-johne-s-disease-in-newborn-calves.aspx …
ಧನ್ಯವಾದಗಳು. Twitter ಇದನ್ನು ನಿಮ್ಮ ಕಾಲರೇಖೆಯನ್ನು ಉತ್ತಮಗೊಳಿಸಲು ಬಳಸುತ್ತದೆ. ರದ್ದುಗೊಳಿಸುರದ್ದುಗೊಳಿಸು -
Ben Swift ಅವರು ಮರುಟ್ವೀಟಿಸಿದ್ದಾರೆ
Delighted to be finalist in 'Breaking Boundaries'
@EDP24 business awards for our rapid test for#bovine#TB, which will radically change the way this infectious disease is detected & controlled.@Mark__Shields@LovewellBlakehttp://bit.ly/2CRBv3Tಧನ್ಯವಾದಗಳು. Twitter ಇದನ್ನು ನಿಮ್ಮ ಕಾಲರೇಖೆಯನ್ನು ಉತ್ತಮಗೊಳಿಸಲು ಬಳಸುತ್ತದೆ. ರದ್ದುಗೊಳಿಸುರದ್ದುಗೊಳಿಸು -
Ben Swift ಅವರು ಮರುಟ್ವೀಟಿಸಿದ್ದಾರೆ
Latest from Alex Pym's group: "DNA directly sequenced from sputum showed significantly more within-sample diversity than that from mycobacterial growth incubator tube culture" cc
@ZaminIqbalhttps://twitter.com/biorxivpreprint/status/1052982870480961536 …ಧನ್ಯವಾದಗಳು. Twitter ಇದನ್ನು ನಿಮ್ಮ ಕಾಲರೇಖೆಯನ್ನು ಉತ್ತಮಗೊಳಿಸಲು ಬಳಸುತ್ತದೆ. ರದ್ದುಗೊಳಿಸುರದ್ದುಗೊಳಿಸು -
Ben Swift ಅವರು ಮರುಟ್ವೀಟಿಸಿದ್ದಾರೆ
With the new ‘Halloween’ arriving in cinemas this weekend, would you like to see a video from a 2016 ‘Baby Driver’ costume fitting of
@iamjamiefoxx dancing up a storm in the Michael Myers mask? Of course you would...pic.twitter.com/VbazBpbAFJಧನ್ಯವಾದಗಳು. Twitter ಇದನ್ನು ನಿಮ್ಮ ಕಾಲರೇಖೆಯನ್ನು ಉತ್ತಮಗೊಳಿಸಲು ಬಳಸುತ್ತದೆ. ರದ್ದುಗೊಳಿಸುರದ್ದುಗೊಳಿಸು -
Ben Swift ಅವರು ಮರುಟ್ವೀಟಿಸಿದ್ದಾರೆ
Claire Pelletier of BioDev
@BioSellal presents new findings from our joint#johnes trial at#EAVLD#vet Congress – showing early detection of M. paratuberculosis in the blood of new born calves using Actiphage& the Bio-T#MAP PCR. Come find us at#EAVLD to find our more!pic.twitter.com/Ph8C3KSRPS ಧನ್ಯವಾದಗಳು. Twitter ಇದನ್ನು ನಿಮ್ಮ ಕಾಲರೇಖೆಯನ್ನು ಉತ್ತಮಗೊಳಿಸಲು ಬಳಸುತ್ತದೆ. ರದ್ದುಗೊಳಿಸುರದ್ದುಗೊಳಿಸು
ಧನ್ಯವಾದಗಳು. Twitter ಇದನ್ನು ನಿಮ್ಮ ಕಾಲರೇಖೆಯನ್ನು ಉತ್ತಮಗೊಳಿಸಲು ಬಳಸುತ್ತದೆ. ರದ್ದುಗೊಳಿಸುರದ್ದುಗೊಳಿಸು -
Ben Swift ಅವರು ಮರುಟ್ವೀಟಿಸಿದ್ದಾರೆ
New trial findings show our Actiphage diagnostic provides reliable, early detection of
#Johnes disease in calves - paving the way for improved disease monitoring & control@BioSellal#EAVLD#vet#MAPhttp://bit.ly/2pWKwQOಧನ್ಯವಾದಗಳು. Twitter ಇದನ್ನು ನಿಮ್ಮ ಕಾಲರೇಖೆಯನ್ನು ಉತ್ತಮಗೊಳಿಸಲು ಬಳಸುತ್ತದೆ. ರದ್ದುಗೊಳಿಸುರದ್ದುಗೊಳಿಸು -
Ben Swift ಅವರು ಮರುಟ್ವೀಟಿಸಿದ್ದಾರೆ
A biotech breakthrough, which looks set to change the face of livestock disease management - reports
@EADT24 on our bovine#TB test. Great piece, thanks@SChambers9! Find out more =>http://www.eadt.co.uk/news/thurston-bury-st-edmunds-firm-s-pioneering-actiphage-tb-test-1-5714763 …ಧನ್ಯವಾದಗಳು. Twitter ಇದನ್ನು ನಿಮ್ಮ ಕಾಲರೇಖೆಯನ್ನು ಉತ್ತಮಗೊಳಿಸಲು ಬಳಸುತ್ತದೆ. ರದ್ದುಗೊಳಿಸುರದ್ದುಗೊಳಿಸು -
Ben Swift ಅವರು ಮರುಟ್ವೀಟಿಸಿದ್ದಾರೆ
This research, co-authored by our CSO and R&D Director, shows the new Actiphage test is a highly sensitive tool that offers a real opportunity for research, to improve our understanding of MAP & its associated diseases
#johnes#crohnshttps://twitter.com/goatvet/status/1040698935801733120 …ಧನ್ಯವಾದಗಳು. Twitter ಇದನ್ನು ನಿಮ್ಮ ಕಾಲರೇಖೆಯನ್ನು ಉತ್ತಮಗೊಳಿಸಲು ಬಳಸುತ್ತದೆ. ರದ್ದುಗೊಳಿಸುರದ್ದುಗೊಳಿಸು -
Ben Swift ಅವರು ಮರುಟ್ವೀಟಿಸಿದ್ದಾರೆ
It's an agar-degrading bacteria, isolated from marine sediment, that can degradre a whole agar plate in just some days
 pic.twitter.com/m6PAOnMuZL
pic.twitter.com/m6PAOnMuZL
ಧನ್ಯವಾದಗಳು. Twitter ಇದನ್ನು ನಿಮ್ಮ ಕಾಲರೇಖೆಯನ್ನು ಉತ್ತಮಗೊಳಿಸಲು ಬಳಸುತ್ತದೆ. ರದ್ದುಗೊಳಿಸುರದ್ದುಗೊಳಿಸು
ಧನ್ಯವಾದಗಳು. Twitter ಇದನ್ನು ನಿಮ್ಮ ಕಾಲರೇಖೆಯನ್ನು ಉತ್ತಮಗೊಳಿಸಲು ಬಳಸುತ್ತದೆ. ರದ್ದುಗೊಳಿಸುರದ್ದುಗೊಳಿಸು
ಲೋಡಿಂಗ್ ಸಮಯ ಸ್ವಲ್ಪ ತೆಗೆದುಕೊಳ್ಳುತ್ತಿರುವಂತೆನಿಸುತ್ತದೆ.
Twitter ಸಾಮರ್ಥ್ಯ ಮೀರಿರಬಹುದು ಅಥವಾ ಕ್ಷಣಿಕವಾದ ತೊಂದರೆಯನ್ನು ಅನುಭವಿಸುತ್ತಿರಬಹುದು. ಮತ್ತೆ ಪ್ರಯತ್ನಿಸಿ ಅಥವಾ ಹೆಚ್ಚಿನ ಮಾಹಿತಿಗೆ Twitter ಸ್ಥಿತಿಗೆ ಭೇಟಿ ನೀಡಿ.














